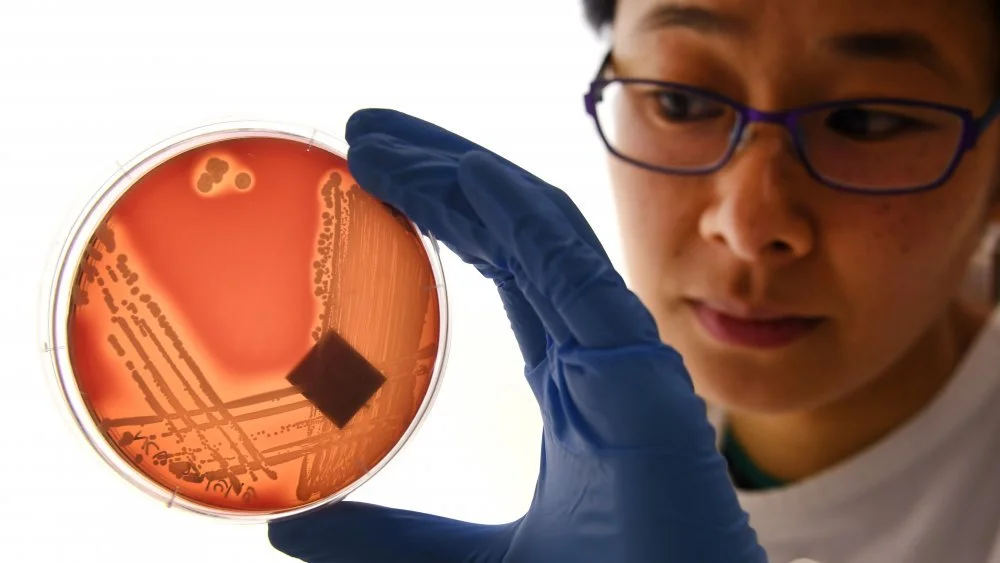
Les prémonitions de pandémies : Qui les a anticipées ?

Sommaire

Ne paniquez pas, bien sûr, il s’agit d’une pandémie, mais ce n’est pas non plus la fin du monde comme dans un scénario d’apocalypse zombie. Inutile de piller les supermarchés ou de chercher un lieu de refuge abandonné. Restez simplement chez vous pendant quelques semaines. Peut-être aurez-vous envie de sécuriser votre réserve de papier toilette, mais à part cela, prenez le temps de vous détendre.
Le COVID-19 représente un danger réel, et il nous appartient à tous de freiner sa propagation. Heureusement, en 2020, nous avons l’avantage de comprendre mieux cet ennemi invisible et de savoir comment nous protéger, du moins en théorie. Il y a peu d’années, la situation était bien différente : les épidémies surgissaient de manière imprévisible, provoquées par un adversaire terrifiant et invisible, et elles se terminaient souvent de façon tragique.
Pourtant, même plusieurs siècles en arrière, certains avaient le pressentiment qu’une catastrophe sanitaire allait survenir. Si seulement leurs avertissements avaient été pris au sérieux, l’histoire n’aurait peut-être pas connu autant de tournants sombres. Ces intuitions sur la menace d’une pandémie illustrent combien la vigilance et la préparation sont essentielles face à ces périls récurrents.

Aujourd’hui, nous bénéficions de milliers d’années d’histoire médicale. Nous disposons de vastes ensembles de données qui nous informent sur la manière dont les virus se propagent, leurs mutations potentielles, les symptômes qu’ils déclenchent et leur taux de mortalité. Grâce à ces connaissances, il est possible d’anticiper les épidémies bien avant qu’elles ne frappent à grande échelle.
Alors, comment se fait-il que personne n’ait vu venir la pandémie de COVID-19 ? En réalité, certains l’avaient anticipée. Pourtant, la plupart des gens préféraient détourner le regard, convaincus que cela ne les concernait pas, continuant leur vie sans restriction ni précaution.
À peine deux ans avant l’apparition du COVID-19, Bill Gates avait tiré la sonnette d’alarme. Oui, Bill Gates, reconnu pour ses engagements dans la santé publique, avait averti que le monde n’était pas prêt à affronter une pandémie, laquelle pourrait potentiellement coûter la vie à des millions de personnes.
Lors d’une intervention organisée par la Massachusetts Medical Society et le New England Journal of Medicine, il a insisté : « Le monde doit se préparer aux pandémies avec autant de sérieux qu’il se prépare à la guerre. » Il soulignait à quel point il est aujourd’hui effrayant de constater la facilité avec laquelle les nouvelles maladies peuvent se propager à l’échelle mondiale. Il avertissait également que la prochaine pandémie ne serait peut-être pas causée par un virus de la grippe classique et que les gouvernements devraient pouvoir mobiliser le secteur privé afin de fournir les outils nécessaires pour lutter efficacement contre ces fléaux.
En rétrospective, cette mise en garde sonnait comme un cri d’alarme prophétique. La question reste donc : pourquoi n’avons-nous pas écouté Bill Gates ?
Un autre visionnaire avait anticipé la pandémie

En janvier dernier, une série documentaire en six épisodes intitulée Pandemic: How to Prevent an Outbreak a été diffusée sans susciter beaucoup d’attention à l’époque. Avec le recul, il est évident que cette œuvre aurait été précieuse pour mieux comprendre les enjeux liés aux pandémies.
Réalisée par Ryan McGarry, médecin urgentiste devenu cinéaste, cette série avait pour objectif d’expliquer au grand public le fonctionnement — ou plutôt le dysfonctionnement — des systèmes médicaux en cas de pandémie. McGarry voulait démontrer comment les professionnels de santé et les institutions se préparent (ou devraient se préparer) à une crise sanitaire majeure.
Malheureusement, la série est arrivée un peu trop tard pour offrir une réelle aide face à la crise actuelle, mais elle demeure essentielle pour mesurer à quel point la société a longtemps fait semblant d’ignorer la menace d’une pandémie. Comme le soulignait McGarry dans une interview, de nombreuses personnes consacrent leur carrière à empêcher la répétition de la terrible grippe de 1918. Pourtant, ces experts voient souvent leur travail marginalisé, leurs budgets coupés, leurs alertes négligées.
Cette série met ainsi en lumière un paradoxe frappant : malgré les avertissements et les préparations, la réalité nous a rattrapés, révélant les failles persistantes dans la gestion des crises sanitaires mondiales.
Le syndrome respiratoire aigu sévère, mieux connu sous l’acronyme SARS, n’a pas atteint l’ampleur de la pandémie provoquée par la COVID-19, mais il a tout de même causé de nombreuses pertes humaines et généré une panique mondiale palpable. En plusieurs aspects, il s’agit d’un véritable « terrain d’entraînement » pour la crise sanitaire actuelle, même si les enseignements tirés à l’époque n’ont pas suffi à nous préparer pleinement. SARS et COVID-19 partagent d’ailleurs une parenté étroite, tant sur le plan viral que dans la nomenclature : le SARS est causé par le virus SARS-CoV, tandis que la COVID-19 résulte de l’infection par le SARS-CoV-2. Ces noms désignent les maladies résultant de ces virus et non les virus eux-mêmes.
En 2003, alors que le SARS commençait à se propager, le Dr Carlo Urbani, chirurgien infectiologue italien, a découvert un patient à l’hôpital français de Hanoï présentant une maladie respiratoire inconnue et sévère, ressemblant la grippe. Face à ce cas inédit, Urbani l’a immédiatement identifié comme une « maladie contagieuse inconnue » et a alerté l’Organisation mondiale de la santé (OMS). Selon les archives de l’OMS, ses mesures rapides ont déclenché une réponse sanitaire mondiale qui a probablement empêché cette épidémie de devenir une pandémie véritablement planétaire.
Mais le Dr Urbani ne s’est pas limité à ce rôle d’alerte initiale. Il est resté sur place pour coordonner les actions de confinement du virus et s’impliquer activement auprès des patients. Malheureusement, son engagement lui a coûté la vie : il a contracté le SARS au contact des malades et est décédé des suites de la maladie, le 29 mars 2003, devenant l’une des premières victimes célèbres de cette épidémie.

John Brownstein a créé un outil qui a anticipé Ebola

La maladie à virus Ebola n’a jamais véritablement atteint le stade de pandémie, pour plusieurs raisons. D’abord, Ebola ne se transmet pas par des gouttelettes en suspension dans l’air, comme c’est le cas pour de nombreuses infections respiratoires. Il faut un contact étroit avec une personne très malade pour contracter Ebola, et inversement, une personne contaminée doit elle-même être gravement malade pour propager le virus. Cette dynamique contraste fortement avec le SARS-CoV-2, contagieux même chez les porteurs asymptomatiques.
L’épidémie mondiale d’Ebola en 2014 reste cependant la plus étendue et la plus violente jamais enregistrée, avec plus de 11 000 décès et 28 000 cas d’infection. Neuf jours avant que l’Organisation mondiale de la santé (OMS) ne déclare officiellement cette épidémie, un outil de suivi des maladies en ligne appelé HealthMap détectait déjà des signes précoces d’une « fièvre hémorragique mystérieuse » dans le sud-est de la Guinée.
Ce détecteur exploitait des algorithmes analysant des données issues des médias, des réseaux sociaux et des sites gouvernementaux. Son cofondateur, John Brownstein, avait pour ambition d’identifier les foyers de maladies très en amont, souvent bien avant les agences de santé publique. Ainsi, cet outil révolutionnaire s’est montré précurseur dans la surveillance épidémique.
Quand la pandémie de COVID-19 a émergé, HealthMap n’a pas tardé à cartographier le virus depuis la Chine jusqu’à des métropoles comme Tokyo, Chicago ou Paris dès le mois de février. Toutefois, malgré ces alertes précoces, la population n’a pas anticipé l’ampleur de la crise. Ce décalage soulève encore aujourd’hui des questions sur la perception collective du risque et la gestion des pandémies à l’échelle mondiale.
Venise, l’inventrice de la quarantaine
Bien des siècles auparavant, les épidémies faisaient partie intégrante du quotidien. Que ce soit la variole, la peste noire ou encore la maladie des sueurs, la population vivait constamment sous la menace de ces fléaux. À cette époque, la pauvreté touchait près de 99,9 % de la population, rendant la vie déjà extrêmement difficile. Dans ce contexte, une nouvelle épidémie semblait presque ordinaire, une fatalité parmi d’autres.
Parmi toutes ces maladies, c’est la peste noire qui a probablement semé le plus d’effroi. Également appelée peste bubonique, elle est provoquée par la bactérie Yersinia pestis, transmise par les puces parasitant les rats noirs. Ces rongeurs étaient omniprésents, suivant souvent les humains pour se nourrir de leurs grains ou déchets, mourant ensuite de maladies, et disséminant ainsi les puces infectées partout où ils passaient.
À l’époque, le mécanisme précis de propagation était inconnu. Cependant, les autorités vénitiennes du milieu du XIVe siècle comprirent rapidement que la contagion se propageait de personne à personne. Plutôt que de se résigner, ils adoptèrent une mesure innovante et précurseure : ils décidèrent d’isoler tous les marins arrivant dans le port pendant une période de 40 jours. Cette précaution visait à s’assurer qu’ils ne transportaient pas la peste avant de leur permettre l’accès à la cité.
Ce protocole strict d’isolement forcé fut appelé « quarantio », terme qui donnera plus tard naissance au mot « quarantaine ». Cette initiative, sans doute la première de ce genre à l’échelle d’une ville, marque une étape fondamentale dans la lutte contre les pandémies et illustre l’ingéniosité dont faisaient preuve certaines sociétés face aux calamités sanitaires.

La plupart d’entre nous imaginent une pandémie comme un événement soudain, frappant sans avertissement et bouleversant des civilisations entières en quelques mois, ne laissant derrière elle que douleur et tombeaux. Pourtant, une pandémie peut aussi s’installer lentement au sein des sociétés. C’est notamment le cas d’une des plus dévastatrices pandémies mondiales qui a mis des années à déployer toute sa portée, et qui sévit encore aujourd’hui, bien que plus lentement, dans certaines régions du globe.
Épidémie connue sous le nom de sida, elle a causé la mort d’environ 32 millions de personnes depuis son identification dans les années 1980. À titre de comparaison, la peste noire — épidémie la plus célèbre de l’Histoire — a tué « seulement » près de 25 millions de personnes. Certes, elle a touché une part plus importante de la population à l’époque, mais en nombre de décès absolus, le sida l’emporte.
En 1986, le Dr David Baltimore, alors président d’un comité scientifique majeur, avertissait que la situation liée au sida était bien plus grave que ce que le gouvernement fédéral laissait entendre. Selon le New York Times, Baltimore affirmait que l’Académie nationale des sciences était « honnêtement effrayée » par le potentiel épidémique du virus. Leur rapport soulignait clairement que « si la propagation du virus n’est pas contrôlée, l’épidémie actuelle pourrait devenir une catastrophe ». Un jugement particulièrement prophétique au regard de ce que nous savons aujourd’hui.

Le virus Zika ne constitue qu’une des nombreuses maladies transmises par les moustiques. Apparenté à la fièvre jaune, à la dengue et au virus du Nil occidental, il est bien plus ancien qu’on ne le croit généralement. Découvert pour la première fois en 1947 chez un singe rhésus, ce n’est toutefois qu’en 2015 que son potentiel pandémique a réellement été perçu.
Au début du mois de mars 2016, le docteur Daniel R. Lucey publie un article dans le Journal of the American Medical Association, décrivant Zika comme une maladie dotée d’un « potentiel pandémique explosif ». À cette période, des foyers d’infection se propageaient dans vingt pays d’Amérique du Nord et du Sud, ainsi qu’en Afrique, en Asie du Sud-Est et dans les îles du Pacifique.
Pourtant, cette menace n’a pas provoqué une panique générale. Zika est en effet responsable de symptômes le plus souvent légers, à quelques exceptions près. Certaines complications rares, telles que le syndrome de Guillain-Barré ou une augmentation du risque de microcéphalie chez les nouveau-nés dont les mères avaient contracté le virus, éveillent toutefois des inquiétudes.
Dans son article, Lucey appelle les organismes de santé publique à émettre des recommandations aux voyageurs et à encourager la lutte contre les moustiques vecteurs, ce qui reste le moyen principal de prévention. Il dénonce également un manque d’action de la part de l’Organisation mondiale de la santé à ce stade.
À l’issue de l’épidémie, un indicateur révélateur montre que le grand public a pris le virus au sérieux : au Brésil, le nombre de naissances a chuté de plus de 100 000, signe d’une inquiétude palpable malgré la relative absence de mesures officielles fortes.

Au printemps 2009, la pandémie de H1N1 a pris tout le monde de court, survenant à la fin d’une saison grippale déjà avancée. Surnommée « grippe porcine », cette infection évoquait par son nom les virus grippaux présents chez les cochons, même si aucune preuve solide n’établit une origine directe de ce virus chez ces animaux. Bien que redoutable, cette grippe porcine n’a toutefois pas engendré la même panique mondiale que celle suscitée par la COVID-19.
Environ 60,8 millions de personnes ont été contaminées aux États-Unis, causant la mort de 12 469 individus. Ces chiffres, tout en étant inquiétants, correspondent à un taux de mortalité général estimé à seulement 0,02 %, ce qui reste inférieur à celui de certaines autres grippes saisonnières, selon les analyses de FactCheck.
Face à cette menace, l’administration Obama a fait preuve d’une vigilance exemplaire : moins de deux semaines après la détection du premier cas américain en Californie, une urgence de santé publique a été déclarée. La réaction fut rapide et coordonnée — dès le même jour, les antiviraux ont été rendus disponibles, un nouveau test diagnostique validé en seulement deux jours, et six mois plus tard, un vaccin a été élaboré.
Cette efficacité s’explique en partie par la longue expérience accumulée avec la grippe saisonnière. Les chercheurs connaissent bien les antiviraux efficaces et les procédés de fabrication des vaccins. En revanche, la COVID-19, étant un virus totalement différent, a contraint les scientifiques à repartir de zéro, ce qui explique en grande partie les délais plus longs observés dans la lutte contre cette nouvelle pandémie.

Sur une échelle du désastre le plus épique, la variole se distingue comme l’un des virus les plus dévastateurs de l’Histoire. Ce fléau a causé la mort de centaines de millions de personnes – notamment environ 300 millions au XXe siècle seulement. Ceux qui survivaient étaient souvent marqués à vie par d’horribles cicatrices. Lorsque les Européens introduisirent la variole en Amérique, elle anéantit sans pitié les populations autochtones, entièrement dépourvues d’immunité naturelle. Durant les Guerres franco-indiennes, ce virus fut même exploité comme arme biologique.
Au milieu du XIXe siècle, tous – ou du moins la majorité – savaient que de telles épidémies pouvaient provoquer des ravages à grande échelle. Peu après que le vapeur Brother Jonathan ait amené le premier cas à Victoria, en Colombie-Britannique, le gouverneur James Douglas, fort de ses précédentes expériences lors d’épidémies de variole, proposa la construction d’un hôpital destiné à contenir la propagation.
Cependant, selon History Link, cette initiative fut rejetée par l’Assemblée législative qui qualifia Douglas « d’alarmiste ». Les opposants jugèrent la création d’un tel établissement trop coûteuse, et allèrent jusqu’à arguer qu’elle porterait atteinte à la liberté des malades. Paradoxalement, les autorités vaccinaient alors la population – mais exclusivement les personnes blanches.
Ce refus de mettre en place une quarantaine stricte et cette inaction fatale eurent des conséquences dramatiques : plus de 14 000 autochtones, non protégés et laissés pour compte, furent victimes de la propagation dévastatrice du virus au sein de leurs communautés.
Vers la fin du mois de janvier 1918, le Dr Loring Miner fut appelé pour examiner un patient présentant des douleurs corporelles, de la fièvre, un mal de tête et une toux sèche. Bien qu’il s’agissait clairement d’une grippe, certains symptômes du patient inquiétèrent particulièrement le médecin. Ils étaient plus sévères que ceux observés lors de grippes habituelles. Rapidement, Miner constata que le virus touchait de manière disproportionnée des adultes jeunes et en bonne santé, causant un taux de mortalité anormalement élevé.
Déterminé à comprendre l’origine de cette maladie, Miner consulta nombre de revues médicales, mena des études dans son laboratoire et tenta même de renforcer le système immunitaire de ses patients en leur administrant des vaccins contre d’autres maladies. Selon le Fort Morgan Times, il alerta également le Service de Santé Publique à propos de cette épidémie. Cependant, à cette époque, la grippe ne figurait pas encore parmi les maladies surveillées par les autorités sanitaires. Pendant une grande partie de l’année, Miner fut le seul à évoquer cette « influenza de type sévère » et ses avertissements restèrent largement ignorés.
Le virus aurait peut-être resté localisé — du fait que les voyages aériens n’étaient pas encore répandus — si la Première Guerre mondiale n’avait pas continué à aggraver la situation. Le mouvement constant des soldats entre les bases, leurs permissions et leurs départs en mission facilitèrent la propagation rapide du virus. Au terme de cette pandémie, on estime à environ 50 millions le nombre de décès causés à travers le monde.

Le déni face aux avertissements de Benjamin Rush

Au printemps 1793, Philadelphie connaît un climat doux et humide, devenu chaud et sec dès le mois de juin. Cette année-là, les moustiques prolifèrent, sans que personne ne soupçonne leur rôle dans la terrible épidémie de fièvre jaune qui va bientôt frapper la ville.
Les premières victimes sont principalement des réfugiés pauvres, des colons français ayant fui une révolte d’esclaves et une autre épidémie dans les Antilles. Ces malades, marginalisés par leur condition sociale, sont largement ignorés, car leur douleur ne suscite d’empathie qu’auprès des plus démunis.
Cependant, selon les archives médicales, un homme, le docteur Benjamin Rush, observe ce qui se passe. Ayant soigné plusieurs malades atteints de fièvre jaune, il pressent dès la mi-août que la ville s’apprête à affronter une épidémie majeure.
En courageux lanceur d’alerte, Rush publie un avertissement public. Mais loin d’être pris au sérieux, il est considéré comme un alarmiste. Les habitants préfèrent ignorer ses conseils et continuent à vaquer à leurs occupations, certains même à faire la fête, refusant de laisser la peur gouverner leurs vies.
Lorsque la dernière semaine d’août arrive, la gravité de la situation est indéniable : les cloches des funérailles retentissent sans interruption, et une grande partie de la population s’enfuit pour échapper à la contagion. Au final, plus de 4 000 personnes succombent à cette crise sanitaire sans précédent.
Benjamin Rush, malgré sa volonté farouche de sauver ses concitoyens, perd sa réputation à cause des traitements sévères et inefficaces qu’il applique. Son histoire illustre tragiquement combien il est difficile d’alerter une société réticente à affronter l’imminence d’une pandémie.